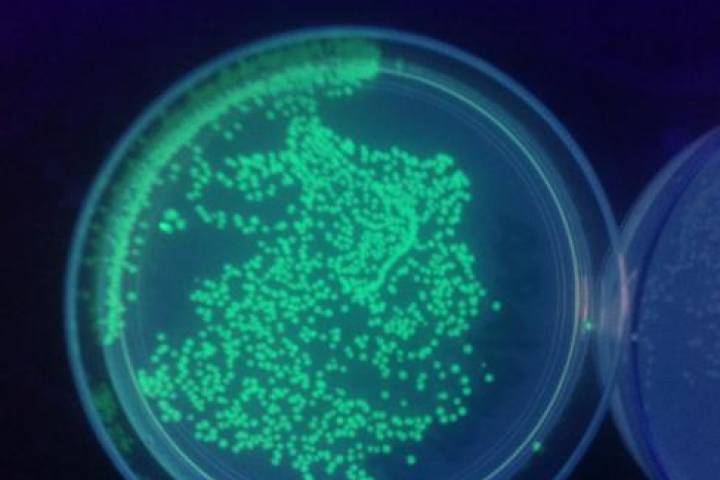

News: Teacher stories
Teachers all over the state and beyond are using Feed the World lessons with their students! See how other teachers are implementing this curriculum in their classrooms, learn about emerging agricultural topics and resources, and get the latest updates on our workshops and satellite activities.
Yes, ANOTHER winner!
Danielle Penrod teaches at Waverly Junior High School, and she attended Feed the World in 2013. She said, “The workshop helped me learn how to teach sixth grade ohio soil science standards in a hands on way. I was able to jump in and teach my kids about soil after the workshop, and they were able to understand that the soil under their feet is …
Jennifer Foudray for the win!
Jennifer Foudray teaches science at Global Impact STEM Academy in Springfield, Ohio. She attended a Feed the World workshop in 2014. She said the workshop was very helpful. “I was able to take content that was taught and apply it in my classroom. Water quality was the main focus.” Foudray is now the proud owner of a supply kit worth over $400. …
FTW alumni Allyssa McMullen WINS!!
Allyssa McMullen teaches at River View High School. She attended the 2015 Feed the World workshop. McMullen said the workshop provided useful tools and ideas for her classroom. “I was able to teach about the ethanol process and the students developed research projects based on that information. We also did some great hands-on lessons including …
Feed the World alum Mary Ann Hopple
Mary Ann Hopple of Athens City Schools attended the Feed the World workshop in 2015. She recently won a teacher kit worth $400, full of supplies to do the FTW labs in her classroom. Hopple found the FTW workshop materials helpful. “I used the water and soil tests to help my students better understand ‘real world’ science applications. I also used …
Trimble students test samples to assess soil quality
Christine Snoddy teaches sixth grade science and social studies at Trimble Middle School in Athens County, Ohio. After attending a Feed the World workshop for teachers, she presented a unit about soil. Snoddy said her goal was to simply introduce the students to what soil is, what nutrients make it healthy for plants, and its importance. “I used a …
Congratulations to Laura Ringler, Ohio ACTE Award Winner!
Laura Ringler has been named the Ohio Association for Career and Technical Education (ACTE) Outstanding New Career and Technical Teacher of 2016. Ringler became the agriculture teacher at Plymouth High School in 2010, and her coursework includes agriculture, food science and technology, natural resources, plant and horticulture science, …
Bacterial transformation a glowing success!
Joe DePalma teaches biology and chemistry at Dublin Coffman High School. He recently took his General Biology students through a pGLO bacterial transformation lab. DePalma placed the students in small groups and arranged the groups in a circle in the classroom, allowing them to talk through each step before moving on. Out of the 16 groups that …
How healthy is your soil?
The River View FFA learned about soil health and soil testing thanks to the donation of a soil test kit from the Ohio Corn Education program. Students were able to take soil samples from various crop fields. Next, they determined the pH, nitrogen, potassium and phosphorus levels in the soil and analyzed the results to see if fertilizer needed to …